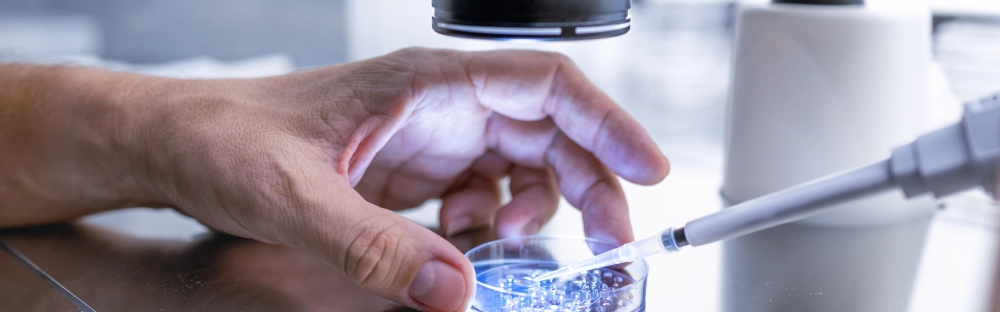
16c049d6a3b6-C-suite-barometer-life-sciences-pharma.jpg.webp 16c049d6a3b6-C-suite-barometer-life-sciences-pharma.jpg.webp

News Update from Forvis Mazars Global
Insights
Forvis Mazars News
You will find here a series of summaries providing an overview of useful regulations, processes and issues for Doing Business in Thailand.
APAC Business Outlook 2026: Reinventing for growth amid disruption

16 March 2026
Persistent trade disruption and geopolitical uncertainty are prompting APAC leaders to shift from a “wait and see” approach to “reinvent and invest.” Based on insights from over 3,000 global C-suite executives, including 260 from APAC, the report shows how volatility is reshaping strategic decisions across the region, from supply chain reconfiguration to accelerated technology investment.
Global private equity outlook 2026: Exploring new investment direction

3 February 2026
The Forvis Mazars global private equity outlook 2026 delivers exclusive insights from over 800 private equity professionals across regions, sectors and investment strategies. Explore our global report and insights into how investor priorities are evolving amid changing market conditions.
C-suite barometer 2026: Adapting in uncertainty

27 January 2026
Our latest study uncovers a business world embracing change, investing in technology and people, and reimagining strategies to stay ahead of disruption and competition. Success now rests on adaptability as much as ambition.
Growing Global

9 October 2025
Navigating global complexity. Delivering business certainty.
Cyber security in 2026: navigating innovation, regulation and resilience

6 October 2025
Cyber security faces a convergence of emerging technologies, evolving regulations and advanced threats. To prepare for what’s next, organisations will need to embrace strategic governance and intentional innovation.
Forvis Mazars for good: Sustainability report 2024

At Forvis Mazars, we are strongly committed to reducing our environmental footprint, generating positive outcomes for our teams and playing an active role in our communities, as well as supporting our clients during these transformative times. This is why, for the sixth consecutive year, we are transparently sharing how we are putting our ESG strategy into action through our annual corporate sustainability report. This report showcases our efforts to create a fairer and more prosperous world, detailing our key impact areas, the challenges we face and how we are working with our many stakeholders to enhance our performance.
C-suite barometer: manufacturing sector view

As global uncertainty reshapes the industrial landscape, manufacturers are under increasing pressure to adapt and compete. Yet many leaders remain confident in their growth ambitions. In this shifting environment, strategic agility is becoming a vital asset. Drawing on perspectives from executives in more than 35 countries, this report explores how manufacturing leaders are responding to change and where they are uncovering new opportunities for growth.
Financial reporting of European banks: benchmark study 2025

As European banks move into 2025 amid renewed U.S. tariffs and heightened geopolitical tensions, is this calm before the storm? Throughout 2024, we observed a continued reduction in credit risk buffers, despite persistent macroeconomic pressures and geopolitical challenges. As we examine the year-end results of the region’s largest institutions, what do the figures reveal about how they manage expected credit losses (ECLs) in an increasingly unpredictable environment?
C-suite barometer: technology, media and telecommunications sector view

From geopolitical unrest to rapid advances in artificial intelligence, 2025 has already proven to be a year of volatility and transformation. In this uncertain environment, strategic agility in the technology, media and telecommunications (TMT) sector is more critical than ever.
C-suite barometer: life sciences & pharmaceuticals sector view
In a year marked by global uncertainty, shifting regulations, and fast-moving innovation, leaders in the life sciences & pharmaceuticals sector are redefining their strategic priorities. Drawing on insights from executives from across more than 35 countries, our latest report captures how sector players are navigating complexity, investing in growth, and positioning themselves for long-term success in a competitive landscape.